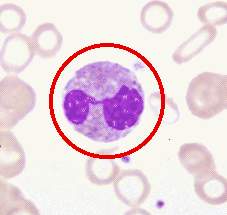
眼弓首線蟲病

流行病學
犬弓蛔蟲是一種在世界各地均有廣泛分布的寄生蟲。美國東南地區感染髮生率高據報導不同地區狗的感染率有很大不同,倫敦的感染率為33%澳大利亞的布里斯班的感染率高達100%。眼犬弓蛔蟲病患者多有養狗史患者血清抗弓蛔蟲抗體多為陽性。發病年齡為2~31歲,但主要見於4~8歲的兒童80%的患者年齡在16歲以下,尚未見性別差異的報導。眼弓首線蟲病被認為是兒童後葡萄膜炎的三大原因(眼弓形蟲病、巨細胞病毒感染和眼弓首線蟲病)之一。據報導眼弓首線蟲病在兒童葡萄膜炎中占10%。
病因
 弓蛔成蟲
弓蛔成蟲人類感染是因吞食被感染犬的受精卵所污染的食物特別是密切接觸犬貓,又不注意衛生的人更容易引起感染。受精卵在小腸內孵化,第2期幼蟲由腸入血液,轉移到肝、心、肺、腦、眼和周圍循環當幼蟲到達血管徑小於其身體之小動脈時則穿過管壁入其所在器官在人體內弓蛔蟲發育不超過第2期,所以在人體內不能繁殖產卵因此人糞便檢查是陰性。幼蟲可在周圍組織內保持為安靜的胞囊狀態而無症狀,但在其移行時則發生急性內臟蚴蟲移行症(VLM)在眼內單個幼蟲即可引起視力喪失。幼蟲可直接經過脈絡膜睫狀體或中心視網膜動脈入眼,在入眼前幼蟲可為胞囊位於周圍組織。
發病機制:此病可通過直接侵犯眼內組織和(或)通過引起免疫應答而引起葡萄膜炎。侵犯至眼內組織的幼蟲常引起慢性玻璃體炎、局灶性壞死性肉芽腫性炎症,特徵地表現為幼蟲周圍嗜酸性粒細胞、類上皮細胞、多核巨細胞、漿細胞和淋巴細胞浸潤。有研究發現患者玻璃體和房水中有高效價的抗弓蛔蟲抗體(IgG、IgE),提示免疫應答在眼弓首線蟲病的發生中可能起著重要作用。
臨床表現
 虹膜
虹膜2.眼部表現 眼部症狀可有眼前黑影、視力下降等視力下降的程度在不同患者可有很大不同一些患者由於年齡較小,往往難以表述確切的臨床症狀。
此病最常見的改變為單側眼底出現肉芽腫性改變,此是由Ⅱ期幼蟲侵犯脈絡膜後形成包囊造成的。肉芽腫可發生於後極部,也可發生於周邊部。後極部病變3/4~3個視盤直徑大小,呈灰色或白色隆起常伴有輕度至重度的玻璃體炎症反應和視力下降。一些患者可出現白瞳症或斜視。周邊部的肉芽腫是一常見的改變,常表現為周邊眼底的白色隆起病灶,易伴有視網膜皺褶。此種皺褶可從周邊部延伸至視盤,周邊部病變有時類似於中間葡萄膜炎的雪堤樣改變。
眼弓首線蟲病尚可引起慢性眼內炎,表現為輕度的前葡萄膜炎、虹膜後粘連、睫狀膜形成、玻璃體炎症和視網膜脫離,偶爾可引起前房積膿視盤炎、黃斑水腫;一些患者還可出現周邊視網膜炎,此可能是幼蟲停滯於周邊視網膜血管內所造成的;在少數患者尚可在視網膜血管內看到活的幼蟲;眼弓首線蟲病尚可引起神經視網膜炎、視網膜分支動脈阻塞、鞏膜炎、角膜炎等。此外尚有弓蛔蟲侵入晶狀體,引起晶狀體腫塊的報導。
併發症:眼弓首線蟲病易引起增殖性玻璃體視網膜病變和牽引性視網膜脫離;所致的睫狀膜收縮可導致睫狀體和脈絡膜脫離,影響房水產生並導致低眼壓;由於患者的視力受到嚴重影響,可出現斜視弱視等併發症。
診斷
 引起的異食癖
引起的異食癖1.臨床表現 主要有嗜伊紅細胞增多特別是眼底有限局性肉芽腫性炎症玻璃體一般混濁顯著。
2.血清ELISA方法 對弓蛔蟲病有高度特異性與其他蠕蟲感染無明顯交叉反應,採用玻璃體檢查,敏感性更高。缺點是一般小實驗室不易開展此種試驗。
3.房水和玻璃體吸取 檢查嗜伊紅細胞。
4.超音波檢查 可發現肉芽腫性病變對眼底不能窺見者更為有利。
檢查
嗜酸性粒細胞
嗜酸性粒細胞2.血清學檢查 血清IgGIgM和IgE通常升高。酶聯免疫吸附試驗測定抗弓蛔蟲抗體是一種穩定和可靠的診斷試驗。所使用的抗原至少有兩種,一種來自胚胎卵,另一種為外抗原。抗體測定有較高的敏感性(90%)和特異性(90%)。一般將抗體效價的截點設在1∶8發現多數患者有陽性結果。隨著選定的截點值(效價)增高,敏感性逐漸下降,但特異性也逐漸升高在疾病過程中特異性抗體效價多隨著病程延長而逐漸降低因此在對特異性抗體測定結果判斷時,一定要與臨床表現結合起來綜合考慮。
對診斷更具有價值的實驗室檢查為房水中抗弓蛔蟲抗體的測定房水抗體效價與血清抗體效價經Goldmann-Witmer公式計算後,Goldmann-Witmer係數超過4時,可確診為眼弓首線蟲病係數在1~4,為可疑眼弓首線蟲病,係數小於1時為陰性。
其它輔助檢查:1.超音波檢查 超音波檢查可為有顯著玻璃體混濁患者的診斷提供重要線索。眼弓首線蟲病的超音波檢查改變有以下3種:①視網膜周邊部高反射固體腫塊;②連線後極部和腫塊的玻璃體膜;③牽引性視網膜脫離或由後極部伸向腫塊的視網膜皺褶。
2.CT檢查 CT檢查發現眼內鈣化灶,有助於鑑別眼弓首線蟲病和視網膜母細胞瘤
治療
 抗蠕蟲藥
抗蠕蟲藥對有眼前段炎症者應給予糖皮質激素、非甾體消炎藥和睫狀肌麻痹滴眼劑點眼治療以使炎症儘快消退並減少虹膜後粘連等併發症的發生。
2.手術治療 睫狀體平坦部玻璃體切割術可用於治療那些藥物治療效果不佳的患者或伴有顯著的玻璃體增殖膜以及牽引性視網膜脫離的患者。可根據患者的具體情況聯合冷凝或光凝治療。如能看到幼蟲且幼蟲位於黃斑區中心凹3mm以外,應進行光凝治療,以殺滅弓蛔蟲。但在行此種治療時應聯合糖皮質激素口服治療。
